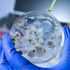
إيبولا تسبب بوفاة 2288 شخصا

أخرى من إقتصاد »

البورصة تفقد 4.3 مليار جنيه من رأسمالها السوقي في نهاية التعاملات
09 سبتمبر 2014 17:06
بالصور | آبل تكشف عن هاتفها الجديد
09 سبتمبر 2014 22:07
برنت ينزل عن 100 دولار تحت وطأة المعروض الوفير
09 سبتمبر 2014 11:11
إسرائيل تجري تجربة صاروخية لتطوير منظومتها الدفاعية
09 سبتمبر 2014 20:10
كيري في الشرق الأوسط لبناء تحالف ضد "داعش" من 40 دولة"
09 سبتمبر 2014 10:08
وفاة اسير فلسطيني في سجن اسرائيلي "في ظروف غامضة"
09 سبتمبر 2014 18:08
«المركزي»: حصيلة شهادات القناة منذ اليوم الأول حتى الآن وصلت 2...
09 سبتمبر 2014 19:14
الملك يدعو لمكافحة ومحاصرة التنظيمات الإرهابية
09 سبتمبر 2014 19:05
باريس تدفع باتجاه عمل عسكري في ليبيا بعد عملية مالي
09 سبتمبر 2014 18:13
لافروف لا يمكن محاربة الإرهاب في سوريا والمطالبة برحيل الأسد
09 سبتمبر 2014 20:21
السجن 20 عاما لقياديين إسلاميين بارزين في مصر
09 سبتمبر 2014 18:08
ساعات قليلة ليشعل آيفون 6 الأسواق
09 سبتمبر 2014 13:12
البنك العربي ينفي امام محكمة اميركية تهمة تمويل حماس
09 سبتمبر 2014 12:08
العربي: أمانة دائمة لمؤتمر مصر المستقبل لمتابعة تنفيذ التوصيات
09 سبتمبر 2014 22:18
حركة الشباب الصومالية تهدد الولايات المتحدة بعد مقتل زعيمها
09 سبتمبر 2014 21:02
اوكسفام : المجتمع الدولي فشل في الاستجابة للازمة السورية
09 سبتمبر 2014 13:11 لا توجد صورالجيش السورى يستعيد السيطرة على قرى فى حماة
09 سبتمبر 2014 22:11
المرصد السوري: انفجار يسفر عن مقتل 28 قياديا في «حركة أحرار ال...
09 سبتمبر 2014 22:06
"الشورى" يوافق على مشروع نظام جمع التبرعات وصرفها داخل المملكة
09 سبتمبر 2014 18:14
الذهب يحوم قرب أدنى مستوياته في 3 أشهر
09 سبتمبر 2014 11:09
السعودية تنفي إعادة العلاقات الدبلوماسية مع النظام السوري "الف...
09 سبتمبر 2014 21:02
محلب للسفير السعودي: المشروعات الضخمة بالمملكة فرصة لاستيعاب ا...
09 سبتمبر 2014 14:06
السيسي وافورقي يتفقان على ضرورة التنسيق بين الدول الأفريقية بم...
09 سبتمبر 2014 19:09
عشاق آبل يبيتون أمام المتاجر في انتظار "آيفون 6"
09 سبتمبر 2014 15:14
إيبولا تسبب بوفاة 2288 شخصا
09 سبتمبر 2014 21:05
سليمان يدعو لإقامة جسور جوية لتسليح الجيش اللبناني
09 سبتمبر 2014 14:07
مقتل أربعة جنود أوكرانيين منذ وقف إطلاق النار
09 سبتمبر 2014 15:14
السبسي زعيم نداء تونس يقدم أوراق ترشحه للانتخابات الرئاسية
09 سبتمبر 2014 18:08
تابع معنا البث المباشر لمؤتمر “أبل” عن “آيفون 6″ والكثير . #ip...
09 سبتمبر 2014 16:01
الداخلية: القبض على 1197 متهماً لتورطهم في تهريب وترويج المخدرات
09 سبتمبر 2014 16:08
وزير الاستثمار في الصين لزيادة التعاون الاقتصادي بين البلدين
09 سبتمبر 2014 15:08
إسرائيل تدعو الاستخبارات العالمية للتعاون ضد "داعش"
09 سبتمبر 2014 18:12
الحكومة العراقية الجديدة تعقد اول اجتماع لها
09 سبتمبر 2014 17:13
البنك الدولي: العالم يواجه ازمة وظائف
09 سبتمبر 2014 17:06
«قرار ملزم» محتمل لمجلس الأمن لكبح سفر المقاتلين الاجانب وملاح...
09 سبتمبر 2014 16:09
المالية: ميكنة دار المحفوظات للحفاظ علي ذاكرة مصر
09 سبتمبر 2014 16:08
موسكو تنفي دنو مقاتلاتها من بارجة كندية بالبحر الأسود
09 سبتمبر 2014 12:12
إسرائيل تشارك بمحاربة تنظيم الدولة استخباريا
09 سبتمبر 2014 09:05
"الإضراب" سلاح نشطاء مصر لمواجهة قانون التظاهر
09 سبتمبر 2014 10:05 لا توجد صوردبي تستهدف استقبال 200 مليون مسافر
09 سبتمبر 2014 15:06
9.7 تقييم السعر المبدئي لـ "الشرقية الوطنية"
09 سبتمبر 2014 14:15
(البورصة) تغلق على ارتفاع في مؤشريها السعري و(كويت15)
09 سبتمبر 2014 13:13 لا توجد صورمطالب بسرعة سداد مستحقات الشركات الاجانب و تيسير الاجراءات و ح...
09 سبتمبر 2014 22:18
أبل تكشف رسمياً عن جهازي آيفون 6 وآيفون 6 بلس
09 سبتمبر 2014 21:02
وزير اﻹسكان: إنارة ''المشروع القومي للطرق'' بالخلايا الشمسية ل...
09 سبتمبر 2014 11:11
وزير خارجية النرويج يصل القاهرة لبحث تطورات الأوضاع بالمنطقة
09 سبتمبر 2014 13:10 لا توجد صورالأحزاب البريطانية الثلاثة الكبرى تدعم منح اسكتلندا سلطات أوسع
09 سبتمبر 2014 10:04
'اعداد برنامج لاصلاح الادارة المالية للدولة'
09 سبتمبر 2014 22:07
اليوم.. محلب يشهد افتتاح المرحلة الثالثة من تطوير شارع المعز
09 سبتمبر 2014 13:10
معتصمو حقوق الإنسان يهددون بالإضراب عن الطعام
09 سبتمبر 2014 21:05
الأسهم الأمريكية تفتتح منخفضة
09 سبتمبر 2014 22:04
محافظ المركزي البريطاني: رفع الفائدة يزداد اقترابا
09 سبتمبر 2014 22:04
المعركة من أجل بنغازي يمكن أن تفتت ليبيا
09 سبتمبر 2014 22:02
اطلاق سراح شخصية بارزة في المعارضة السودانية
09 سبتمبر 2014 21:14 لا توجد صوربريطانيا سترسل بنادق آلية وذخيرة للجيش العراقي والأكراد
09 سبتمبر 2014 21:14
مئات الاف السكان معزولون عن العالم نتيجة فيضانات الهند وباكستان
09 سبتمبر 2014 18:08
وزير النقل: نخطط لتطوير ميناء شرق التفريعة
09 سبتمبر 2014 14:10
"الداخلية": تنسيقنا مع الدول المجاورة أسهم في ضبط شبكة لتهريب ...
09 سبتمبر 2014 21:11
شركات النفط الروسية الكبيرة على قائمة العقوبات الأوروبية - إيلاف
09 سبتمبر 2014 15:04
مواجهات وضحايا قرب مقر رئاسة الوزراء بصنعاء
09 سبتمبر 2014 15:14أخبار ساخنة من إقتصاد »
جديد من إقتصاد »
- جمعية مصنعي القاهرة الجديدة تبحث فرص التعا...
- خدمة العملاء بالمقدمة.. ما الوظائف الأكثر ...
- رئيس غرفة صناعة الحبوب: 40% زيادة في سعر ا...
- "حماية المنافسة" يكشف اتفاق 21 عيادة جلدية...
- الغرفة التجارية: 30% انخفاضًا في أسعار الخ...
- تيسلا Supercahrge تتخطى 30,000 نقطة عالمياً
- اقتصاد منطقة اليورو ينمو بـ 2.2% في الربع ...
- للمرة الثانية.. البرلمان يطيح بمرشح الرئيس...
- مجلس الوزراء: السماح للجهات الحكومية بـ«ال...
- حفتر يترشح للرئاسة: ليس طلبا للسلطة
- تقنية الأحساء والزراعة تدشنان 100 شتلة ضمن...
- أمانة عسير تُعالج 31 ألف بلاغ عن التشوهات ...
- «الصحة»: 37 إصابة جديدة بـ«كورونا» ووفاتان...
- حزب تونسي يدعو إلى تفكيك «الأخطبوط الإخواني»
- كسر جمجمة شرطي بولندي في مواجهات مع مهاجرين
- القصاص من مقيم قتل مواطناً بإطلاق النار عل...
- «الأرصاد»: انخفاض الحرارة إلى 6 درجات في 4...
- صفقات وتعهدات باستثمارات ضخمة في القارة ال...
- الإمارات تستضيف معرض ومؤتمر «سايبر تك جلوب...
- الإمارات تعلن عن استثمارات جديدة بقيمة 6 م...


